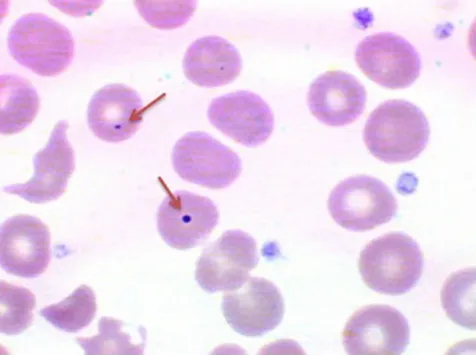
Howell-Jolly bodies in red blood cells (hyposplenism)

Spleen Anatomy & Function - The Body's Blood Filter
- Anatomy: Located in the LUQ, the spleen is composed of two main types of tissue:
- Red Pulp: The majority of the spleen; filters blood to remove old/damaged RBCs and pathogens. Contains sinusoids and Cords of Billroth.
- White Pulp: The immune center; contains Periarteriolar Lymphoid Sheaths (PALS) rich in T-cells and follicles with B-cells.
- Key Functions:
- Filtration: Removes senescent erythrocytes and circulating bacteria.
- Immunity: Site of immune response to blood-borne antigens.
- Storage: Sequesters platelets (approx. 30% of total body supply).

⭐ Asplenic individuals are highly susceptible to overwhelming infection by encapsulated bacteria (e.g., S. pneumoniae, H. influenzae, N. meningitidis).
Splenomegaly - The Oversized Filter
Enlargement of the spleen, typically defined as a weight >500 g or a length >12 cm. It arises from an exaggerated execution of the spleen's primary functions or from pathologic infiltration.
- Pathophysiology & Key Causes:
- Clinical Features: Often asymptomatic. May present with LUQ pain/fullness, early satiety.
- Diagnosis: Palpation (Traube's space percussion), confirmed with ultrasound.
⭐ Massive splenomegaly (spleen >1000 g or extending >8 cm below the left costal margin) is highly suggestive of a myeloproliferative neoplasm (e.g., CML, primary myelofibrosis), hairy cell leukemia, or Gaucher disease.
Splenic Lesions - Cysts, Cancers & Clots
-
Splenic Infarction
- Cause: Embolism (e.g., infective endocarditis), local thrombosis (e.g., sickle cell disease, myeloproliferative neoplasms).
- Morphology: Pale, wedge-shaped, subcapsular lesions. Over time, they heal into fibrotic scars.

-
Splenic Cysts
- True Cysts (Parasitic): Most commonly caused by Echinococcus granulosus.
- Pseudocysts: No cellular lining; account for ~80% of non-parasitic cysts. Often post-traumatic.
-
Splenic Neoplasms
- Benign: Hemangioma is the most common primary neoplasm of the spleen.
- Malignant: Metastases are uncommon. Most malignancies are lymphomas or leukemias.
⭐ Hairy Cell Leukemia classically causes massive splenomegaly due to infiltration of the red pulp, leading to a characteristic "beefy red" appearance.
Hyposplenism & Asplenia - Life Without a Filter
- Etiology: Surgical removal (splenectomy), congenital (asplenia), or functional (e.g., sickle cell disease, celiac disease).
- Pathophysiology: Impaired filtration of blood and ↓ phagocytosis of opsonized bacteria, leading to immune compromise.
- Peripheral Smear Findings:
- Howell-Jolly bodies: Nuclear remnants in RBCs (pathognomonic).
- Target cells, thrombocytosis, lymphocytosis.
⭐ Overwhelming Post-Splenectomy Infection (OPSI): A medical emergency with high mortality. Risk is lifelong but highest <2 years post-splenectomy.
- High-Risk Pathogens: Encapsulated bacteria.
- 📌 SHiN: S. pneumoniae, H. influenzae type b, N. meningitidis.
- Management: Vaccinations, prophylactic antibiotics.
- Splenomegaly is the most common sign, often from portal hypertension or extramedullary hematopoiesis.
- Hypersplenism triad: splenomegaly, cytopenias, and resolution post-splenectomy.
- Splenic infarcts are typically pale, wedge-shaped lesions, often seen in sickle cell disease.
- Massive splenomegaly is a hallmark of Hairy Cell Leukemia (red pulp infiltration) and myelofibrosis.
- In Hereditary Spherocytosis, splenomegaly results from work hypertrophy as the spleen removes defective RBCs.
Unlock the full lesson and continue reading
Signup to continue reading this lesson and unlimited access questions, flashcards, AI notes, and more